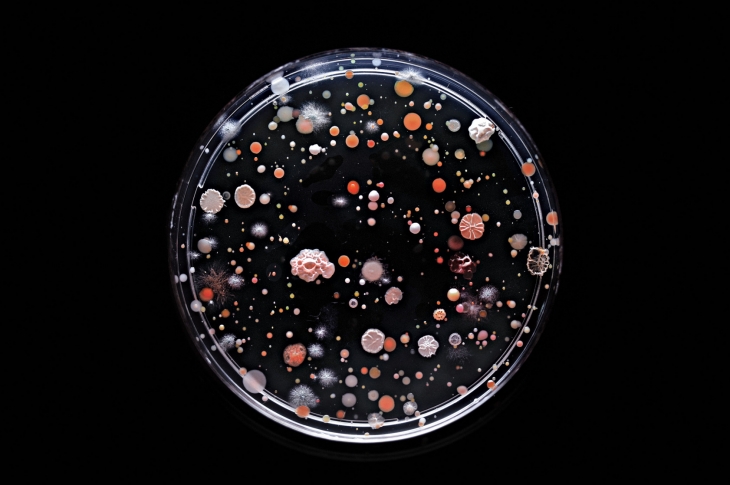
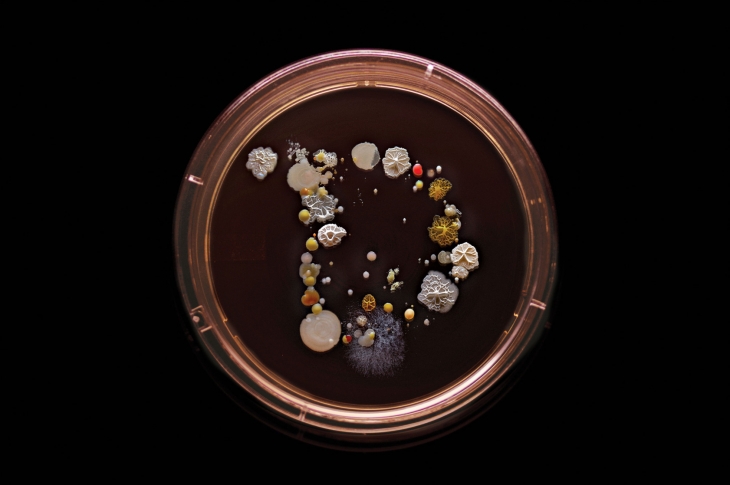
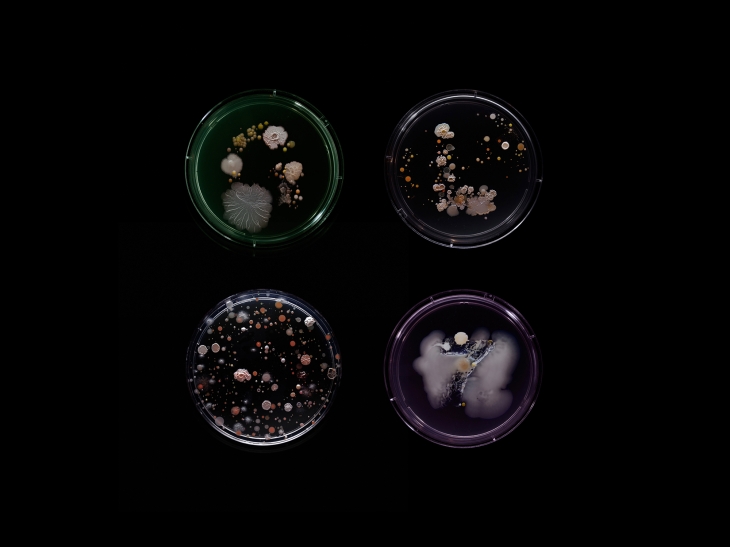

İnsan bedenini diğer canlılara göre ölçeklediğimizde insan her zaman mutlak 1 olur. İnsandan küçük ve insandan büyükler olarak da nesneler ve canlılar sınıflandırılır. Bir yanda evler, binalar, filler, balinalar, gezegenler, galaksiler; öte yanda ise kedi, kuş, böcek, nacizane bakteriler, tek hücreliler ve niceleri. Bu devasa ekosistem içerisinde yaşadığımız dünya aslında ölçeğimize göre daha küçük ve büyük farazi dünyalara da ayrılıyor.
Craig Ward, dünyanın en büyük şehirlerinden biri olan New York’taki örnek ulaşım sistemlerinden biri olan metroda yolculuk yaparken bu detaylardan birisine takılıyor; bakterilere. Bu merakıyla birlikte yepyeni bir dünyaya, sanat çalışmasına ve bireysel bir yolculuğa çıkmış. New York’daki 22 farklı metro hattındaki araçlardaki tutacakları inceliyor ve üzerinden bakteri örneği topluyor.
Hijyen, temizlik ve toplu taşıma araçlarının temizliği göreceli bir kavram olsa da Ward’un karşılaştığı bakteriler arasında; Serratia marcescens (Hastane ortamında yaşayabilen ve çevrel hastalıkları toplayan bir tür), Serratia marcescens (sinüzit, deri enfeksiyonu ve gıda zehirlenmesine neden olan bir tür) gibi zararlı bakteriler olsa da insan sağlığına zarar vermeyen türler de bulunuyor.
Kitaplaştırdığı ve tekil basıma hazırladığı çalışmayı Craig Ward’un çevrimiçi mağazasından ulaşabilirsiniz.

Görsel; Craig Ward







